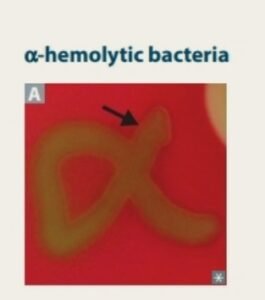

📜 Why Am I Learning This? — The Green Halo Story (α-Hemolysis)
🌟 The Big Why (toddler-simple)
We learn about α-hemolytic bacteria so we can tell friendly look-alikes apart and give the right help in Bodyland.
We learn about α-hemolytic bacteria so we can tell friendly look-alikes apart and give the right help in Bodyland.
Tiny details on a red plate (blood agar) guide big choices like which medicine to use.
Spotting a green halo can point us toward Streptococcus pneumoniae or the Viridans streptococci team.
Right name → right care → faster healing.
🎢 Life description — The Playground Paint
Imagine a school with a red-painted playground. Kids come to play.
Some smash and make holes (not today). Our kids are gentle — they walk softly and leave a faint green smudge, not a hole.
That gentle smudge is alpha (α) hemolysis.
When the teacher puts a “no-entry” Optochin cone down, one kid is shy and backs away (optochin sensitive),
the other is brave and plays near the cone (optochin resistant).
Boom — now you can tell which kid is which!
🔬 Why it matters in clinic
- Find the culprit fast: Green halo on blood agar tells us “think α-hemolysis.”
- Pick the right germ: Streptococcus pneumoniae = optochin sensitive.
Viridans streptococci = optochin resistant. Both are Gram-positive cocci and catalase-negative. - Treat wisely: Naming the germ helps choose proper antibiotics and protect Bodyland’s good flora.
🧠 Tiny Dictionary (made friendly)
α-hemolysis: gentle nibble → green/brown halo, no clear hole.
Blood agar: the red jelly playground where we watch germ manners.
Gram-positive cocci: purple-coat, round germs (bead-shaped).
Catalase-negative: no bubble fizz with peroxide (streps don’t fizz).
Optochin: test disc; shows shy (sensitive) vs brave (resistant).
🧩 Mnemonics (stick-to-brain helpers)
“Alpha = Apple bruise” → a bruise looks green, not a hole.
“OVRPS” → Optochin: Viridans Resistant, Pneumococcus Sensitive.
“Viridans = Verde” → verde = green → green halo.
🙏 Spiritual/Biblical reflection
Small signs guide big decisions. God teaches us to notice the little things:
“He who is faithful in very little is faithful also in much” (Luke 16:10).
May we be gentle detectives in Bodyland, using tiny halos to bring big healing.
🎒 One-Minute Recap
See green halo on blood agar? Think α-hemolysis.
Both Streptococcus pneumoniae and Viridans streptococci are Gram-positive cocci, catalase-negative.
Use optochin: pneumoniae = sensitive, viridans = resistant.
That’s why we learn it — tiny color, mighty clue.
📝 Quick self-check
Q: Green halo, no clearing. The colony avoids the optochin disc. Who is it?
A: Streptococcus pneumoniae (optochin sensitive) avoids the disc.
If it doesn’t avoid, think Viridans. (Use OVRPS!)
